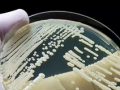
Potentially deadly fungal disease spreading in California - Hindi News | Potentially deadly fungal disease spreading in California | Latest health News at Lokmattimes.com

New Delhi, Sep 6 Health Ministry on Friday approved a new, shorter and more effective treatment regimen for ... ...

![Researchers develop new method to predict severity of breast cancer - Hindi News | Researchers develop new method to predict severity of breast cancer | Latest health News at Lokmattimes.com Researchers develop new method to predict severity of breast cancer - Hindi News | Researchers develop new method to predict severity of breast cancer | Latest health News at Lokmattimes.com]()
New Delhi, Sep 6 A team of researchers has made a major advancement in the severity prediction of ... ...
![India’s Average Household Food Spending Falls Below 50% for First Time: Govt Report - Hindi News | India’s Average Household Food Spending Falls Below 50% for First Time: Govt Report | Latest health News at Lokmattimes.com India’s Average Household Food Spending Falls Below 50% for First Time: Govt Report - Hindi News | India’s Average Household Food Spending Falls Below 50% for First Time: Govt Report | Latest health News at Lokmattimes.com]()
New Delhi, Sep 6: Significant changes are unfolding in India’s food consumption pattern and the share of total household ... ...
![South Korea open to readjusting medical school quota - Hindi News | South Korea open to readjusting medical school quota | Latest health News at Lokmattimes.com South Korea open to readjusting medical school quota - Hindi News | South Korea open to readjusting medical school quota | Latest health News at Lokmattimes.com]()
Seoul, Sep 6 South Korean President Yoon Suk Yeol is open to readjusting the country's medical school admission ... ...
![Digital healthcare solutions should bring ease of living to all: Dr VK Paul - Hindi News | Digital healthcare solutions should bring ease of living to all: Dr VK Paul | Latest health News at Lokmattimes.com Digital healthcare solutions should bring ease of living to all: Dr VK Paul - Hindi News | Digital healthcare solutions should bring ease of living to all: Dr VK Paul | Latest health News at Lokmattimes.com]()
New Delhi, Sep 6 A strong primary healthcare system can reduce the burden in later ages and digital ... ...
![Potentially deadly fungal disease spreading in California - Hindi News | Potentially deadly fungal disease spreading in California | Latest health News at Lokmattimes.com Potentially deadly fungal disease spreading in California - Hindi News | Potentially deadly fungal disease spreading in California | Latest health News at Lokmattimes.com]()
Sacramento, Sep 6 Valley Fever, a fungal disease, has been spreading in California, with warnings from state health ... ...
![Researchers find connection between Alzheimer's & night time light pollution - Hindi News | Researchers find connection between Alzheimer's & night time light pollution | Latest health News at Lokmattimes.com Researchers find connection between Alzheimer's & night time light pollution - Hindi News | Researchers find connection between Alzheimer's & night time light pollution | Latest health News at Lokmattimes.com]()
New Delhi, Sep 6 A team of US researchers on Friday said that they have found a connection ... ...
![Congo receives first batch of mpox vaccines - Hindi News | Congo receives first batch of mpox vaccines | Latest health News at Lokmattimes.com Congo receives first batch of mpox vaccines - Hindi News | Congo receives first batch of mpox vaccines | Latest health News at Lokmattimes.com]()
Kinshasa, Sep 6 A first batch of 99,100 doses of mpox vaccines was delivered to Congo, the epicentre ... ...
![Study finds how infections after hip replacement increases risk of death - Hindi News | Study finds how infections after hip replacement increases risk of death | Latest health News at Lokmattimes.com Study finds how infections after hip replacement increases risk of death - Hindi News | Study finds how infections after hip replacement increases risk of death | Latest health News at Lokmattimes.com]()
Toronto [Canada], September 5 : According to new research, patients who experience a periprosthetic joint infection (PJI) following ... ...
![Malta joins other EU states to curb monkeypox spread in Africa - Hindi News | Malta joins other EU states to curb monkeypox spread in Africa | Latest health News at Lokmattimes.com Malta joins other EU states to curb monkeypox spread in Africa - Hindi News | Malta joins other EU states to curb monkeypox spread in Africa | Latest health News at Lokmattimes.com]()
Valletta, Sep 5 Malta has joined other European Union (EU) member states to help Africa reduce further spread ... ...